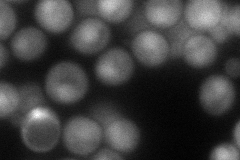
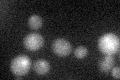

View description
Subunit of the heme-activated, glucose-repressed Hap2p/3p/4p/5p CCAAT-binding complex, a transcriptional activator and global regulator of respiratory gene expression; contains sequences contributing to both complex assembly and DNA binding
Localization:
Intensity:
Fold change:
Significance:
-
C’ GFP library in SD

below threshold20.24 -
N' NOP1pr-GFP in SD

cytosol,nucleus63.7151 -
N' TEF2pr-mCherry in SD
nucleus69.4632 -
N' NATIVEpr-GFP in SD

nucleus26.4944 -
N' TEF2pr-VC and Cyto-VN in SD

#N/A0 -
C’ GFP library in SD+DTT
cytosol16.210.8No -
C’ GFP library in SD+H2O2

cytosol18.160.89No -
C’ GFP library in Starvation Media

cytosol15.970.78No -
C’ GFP library on the background of Pup2-DaMP

below threshold -
C’ GFP library on the background of CCT mutant

below threshold16.93250.836374No
